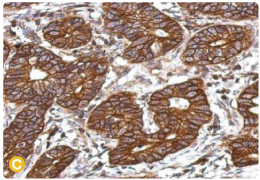
新闻图片9

推荐产品
公司新闻/正文
由肿瘤微环境寻找髓母细胞瘤潜力新疗法-C3a受体与TNF-α受体拮抗剂
574 人阅读发布时间:2023-03-20 09:29

髓母细胞瘤是什么?
髓母细胞瘤(Medulloblastoma, MB)是好发于儿童、主要位于小脑的原发性脑部肿瘤。治疗方法以手术切除为主,辅以化学及放射治疗。尽管由于医学知识与技术的进展,提高了五年存活率,但有幸存活的患者还是必须承受当前强化治疗引发严重并发症的风险。也正因如此,开发更为有效、更具耐受性的治疗方案至关重要,而其中首要之务正是了解MB发生的分子机制 (1)。
补体系统是什么?
Bordet于1896年发现了血清中存在着非耐热物质,此物质具有调理与杀死病原体的作用,可以「补充」抗体对抗外来病原的免疫力,也因此得名「补体」。补体系统(Complement system)包含存在于血浆与细胞表面等30余种蛋白,属于先天免疫的一环。补体系统可以透过经典(Classical)、甘露糖结合凝集素(Mannose-binding lectin, MBL )与替代(Alternative)三种主要路径激活(2)(参见图一)。
在经典路径中,补体蛋白C1q与抗原-抗体免疫复合物结合时,可以激活补体蛋白C1r和C1s,进一步切割并激活补体蛋白C4与C2。甘露糖结合凝集素路径则是藉由凝集素与微生物表面的甘聚露糖结合,激活补体蛋白C4与C2。这两条路径所产生的C3转化酶 (C4bC2a)可以将补体蛋白C3分解成C3b与C3a。在替代路径中,补体蛋白C3可以直接透过水解产生C3b与C3a,无须经由转化酶的作用。在三条路径下游,经由级联反应激活的补体效应蛋白能够做为化学趋化因子、过敏毒素、细胞膜攻击复合物(Membrane Attack Complex, MAC)、可溶性末端补体复合物(Soluble Terminal Complement Complex, sTCC)与调理素等等,协助抵御病原体的入侵 (2)。
 |
| 图一、补体系统激活路径 |
C3a受体与TNF-alpha受体在髓母细胞瘤微环境中扮演的角色
随着人们越来越关注各种癌症的肿瘤微环境(Tumor microenvironments, TMEs),干预治疗的全新契机得以浮现。Gong等人的新研究指出了一项关于肿瘤相关星形胶质细胞(Tumor-associated astrocytes, TAAs)的重大发现:肿瘤相关星形胶质细胞无论在原发性或是续发性的髓母细胞瘤微环境中都扮演了关键的角色 (3)。
在髓母细胞瘤微环境中,补体蛋白C3会被激活,并生成具有促炎性的C3a片段。C3a透过与肿瘤相关星形胶质细胞表面的C3a受体结合,得以进一步激活p38 MAPK途径,并引发下游IL-6和TNF-α的基因表现。释出后的TNF-α会与髓母细胞瘤细胞表面的TNF-α受体结合,并刺激肿瘤细胞的增殖。Gong等人在in vivo与in vitro实验中证实了使用p38 MAPK途径抑制剂、C3a受体拮抗剂或TNF-α受体拮抗剂都能成功抑制此增殖。这说明了髓母细胞瘤微环境中的肿瘤相关星形胶质细胞能够利用C3-p38 MAPK-TNF-α路径,影响肿瘤的恶化。作者等人不只证明了补体系统在肿瘤相关星形胶质细胞调控肿瘤细胞恶化过程中所扮演的角色,还揭示了C3a受体或TNF-α受体拮抗剂做为治疗方法的潜力 (3)。
GeneTex为推动癌症研究发展,提供了多样化且经充分验证的抗体试剂清单。欲了解相关产品,请参考以下重点商品、相关文宣品或造访我们的网站www.genetex.com以获取更多信息。
重点产品 |






|
|
C3 / C3b antibody [C3], C-term (GTX101316)
C3a Receptor antibody (GTX114293)
C3 antibody [HL1643] (GTX637224)
TNF alpha antibody [HL1579] (GTX637058)
p38 MAPK antibody [HL1006] (GTX635797)
IL-6 antibody [HL1168] (GTX636473)
|
重点产品 |
| 目录号 | 产品名 | 应用 |
| GTX101316 | C3 / C3b antibody [C3], C-term | WB, ICC/IF, IHC-P, IP, Immunosubtraction |
| GTX637224 | C3 antibody [HL1643] | WB, ICC/IF |
| GTX114293 | C3a Receptor antibody | WB, IHC-P, IHC-Fr |
| GTX636725 | GFAP antibody [HL1307] | WB, IHC-P, IHC-Fr |
| GTX108711 | GFAP antibody | WB, ICC/IF, IHC-P, IHC-Fr, IHC |
| GTX635363 | Iba1 antibody [HL22] | WB, ICC/IF, IHC-P, IHC-Fr |
| GTX635400 | Iba1 antibody [HL22-RT] | WB, IHC-P, IHC-Fr |
| GTX635399 | Iba1 antibody [HL22-MS] | WB, IHC-P, IHC-Fr |
| GTX632426 | Iba1 antibody [GT10312] | WB, ICC/IF, IHC-P, IHC-Fr, FACS, IHC, IHC (Free Floating) |
| GTX100042 | Iba1 antibody | WB, ICC/IF, IHC-P, IHC-Fr, FACS, IHC, IHC (Free Floating) |
| GTX110543 | Caspase 3 antibody | WB, ICC/IF, IHC-P, IHC-Fr, IP |
| GTX636810 | Caspase 3 antibody [HL1370] | WB, IHC-P |
| GTX133460 | p38 MAPK (phospho Thr180/Tyr182) antibody | WB |
| GTX635797 | p38 MAPK antibody [HL1006] | WB |
| GTX110720 | p38 MAPK antibody [N1C3-2] | WB, ICC/IF, IHC-P |
| GTX110527 | IL6 antibody | WB, ICC/IF, IHC-P, IHC-Fr |
| GTX636473 | IL6 antibody [HL1168] | WB, ELISA, Sandwich ELISA |
| GTX110520 | TNF alpha antibody | WB, ICC/IF, IHC-P, IHC-Fr |
| GTX637058 | TNF alpha antibody [HL1579] | WB |
查看相关内容
(1) 单页 - 癌症干细胞(2) 单页 - MAPK Pathway
(3) 挂图 - 免疫反应
(4) 小星狮谈科研 - 胆固醇载体也可以治疗阿尔茨海默氏症? (2020-03-17)
参考文献
-
Nat Rev Dis Primers. 2019 Feb 14;5(1):11. doi: 10.1038/s41572-019-0063-6.
-
Cell Res. 2010 Jan;20(1):34-50. doi: 10.1038/cr.2009.139. Epub 2009 Dec 15.
-
J Neuroinflammation. 2022 Jun 20;19(1):159. doi: 10.1186/s12974-022-02516-9.
更多详情请联系欣博盛生物科技
全国服务热线:4006-800-892
邮箱:market@neobioscience.com
深圳:0755-26755892
北京:010-88594029
上海:021-34613729
广州:020-87615159